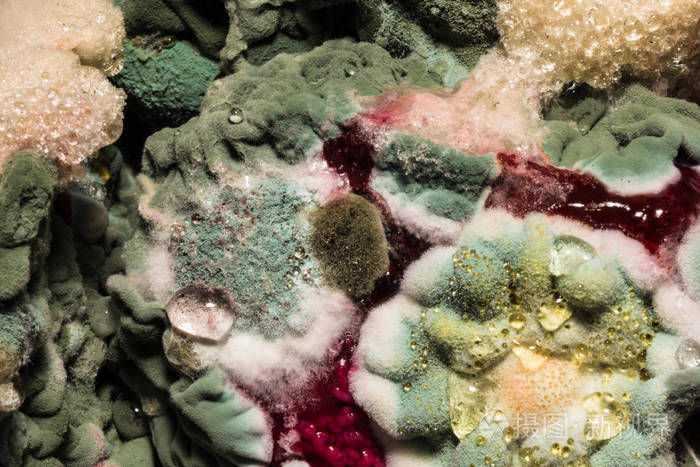
被宠坏的食物上的有色霉菌的密集的形成抽象背景
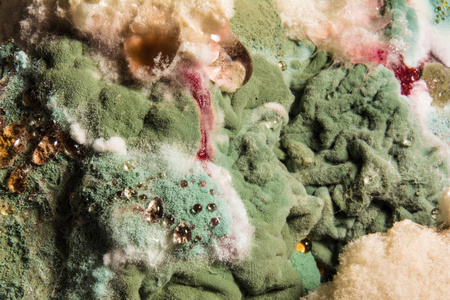
被宠坏的食物上的有色霉菌的密集的形成, 抽象背景照片

霉菌污染

沈阳一大学新宿舍楼现大量霉菌 校方称晾衣服所致
图片尺寸600x800
霉菌污染无处不在.png
图片尺寸750x750
霉菌图片
图片尺寸467x350
被宠坏的食物上的有色霉菌的密集的形成抽象背景
图片尺寸700x467
腐烂食物的表面长着黄霉菌.
图片尺寸1200x800
自 1960 年发现黄曲霉毒素后,霉菌毒素对食品的污染日益受到世界各国
图片尺寸4404x3137
制药厂洁净区霉菌孢子怎么杀灭
图片尺寸1080x608
如何控制霉菌污染食品?金华勇洁净车间臭氧杀菌处理!
图片尺寸1080x720
面包是一种容易受到霉菌污染的食品,而了解促使面包霉菌生长最快的
图片尺寸640x427
霉--霉菌污染食物
图片尺寸550x366
有的甚至已经被霉菌产生了毒素污染
图片尺寸640x425
印象霉菌毒素毒性是砒霜的68倍蓄积残留二次污染这就是个破坏养殖场
图片尺寸1080x720
霉菌mould
图片尺寸1280x853
新玉米霉菌污染严重
图片尺寸1368x1824
被宠坏的食物上的有色霉菌的密集的形成, 抽象背景照片
图片尺寸450x300
揭秘超级致癌物:黄曲霉菌,你身边的潜在健康威胁!
图片尺寸640x960
霉菌mould
图片尺寸1280x853
被宠坏的食物上有色霉菌的密集形成, 抽象特写背景
图片尺寸700x467
霉菌作为为微污染源中的一种,是产品受到二次污染不可忽视的主要原因
图片尺寸800x468
霉菌大 揭秘
图片尺寸2000x2667